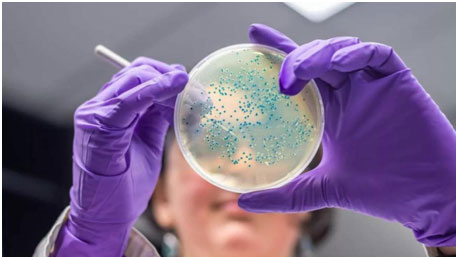

結(jié)腸直腸癌新希望,新的治療靶點已被發(fā)現(xiàn)
醫(yī)學(xué)資訊
|
閱讀量:次
多倫多大學(xué)的研究人員發(fā)現(xiàn)了一種支持多種結(jié)腸直腸癌生長的關(guān)鍵蛋白質(zhì)。這項研究發(fā)表在12月27日《細胞生物學(xué)》雜志上。

該研究揭示了一種名為Importin-11的蛋白將引起癌癥的蛋白β-catenin轉(zhuǎn)運到結(jié)腸癌細胞的細胞核中,從而驅(qū)動細胞增殖。抑制這一轉(zhuǎn)運步驟可能會阻止大多數(shù)由β-catenin水平升高引起的結(jié)直腸癌的生長。
大約80%的大腸癌與APC基因突變相關(guān),該突變導(dǎo)致β-catenin蛋白水平升高。β-catenin的水平升高,隨后蛋白質(zhì)在細胞核中的積累,在蛋白質(zhì)中β-catenin可以激活眾多驅(qū)動細胞增殖,促進結(jié)直腸腫瘤生長和維持的基因。
但人們對β-catenin水平升高后如何進入細胞核的了解卻很少?!坝捎讦?catenin核轉(zhuǎn)運的分子機制尚不清楚,我們著手確定具有APC突變的結(jié)直腸癌細胞中連續(xù)β-catenin活性所需的基因,”多倫多大學(xué)萊斯利分校藥物科學(xué)系教授StephaneAngers說。

Angers團隊使用CRISPRDNA編輯技術(shù),開發(fā)了一種新技術(shù),使他們能夠在人類基因組中篩選支持β-catenin在大腸癌細胞中活性的基因,βcatenin水平已因APC突變而升高。他們鑒定出的主要基因之一是IPO11,它編碼一種叫做Importin-11的蛋白質(zhì),這種蛋白質(zhì)已知與核輸入有關(guān)。
Angers團隊發(fā)現(xiàn),Importin-11與β-catenin結(jié)合并陪伴其進入具有APC突變的大腸癌細胞核。從這些細胞中去除Importin-11可阻止β-catenin進入細胞核并激活其靶基因。
研究人員發(fā)現(xiàn),Importin-11水平在人類大腸癌中經(jīng)常升高。此外,去去除Importin-11可以抑制從患者中分離出的APC突變癌細胞形成的腫瘤的生長。
“我們得出結(jié)論,Importin-11是結(jié)直腸癌細胞生長所必需的,”Angers說。了解有關(guān)Importin-11如何將β-catenin轉(zhuǎn)運到細胞核中的更多信息,有助于研究人員開發(fā)新的療法來阻斷該過程,并減少由APC突變引起的結(jié)直腸癌的生長。
2019-12-20 16:40
好醫(yī)友小編